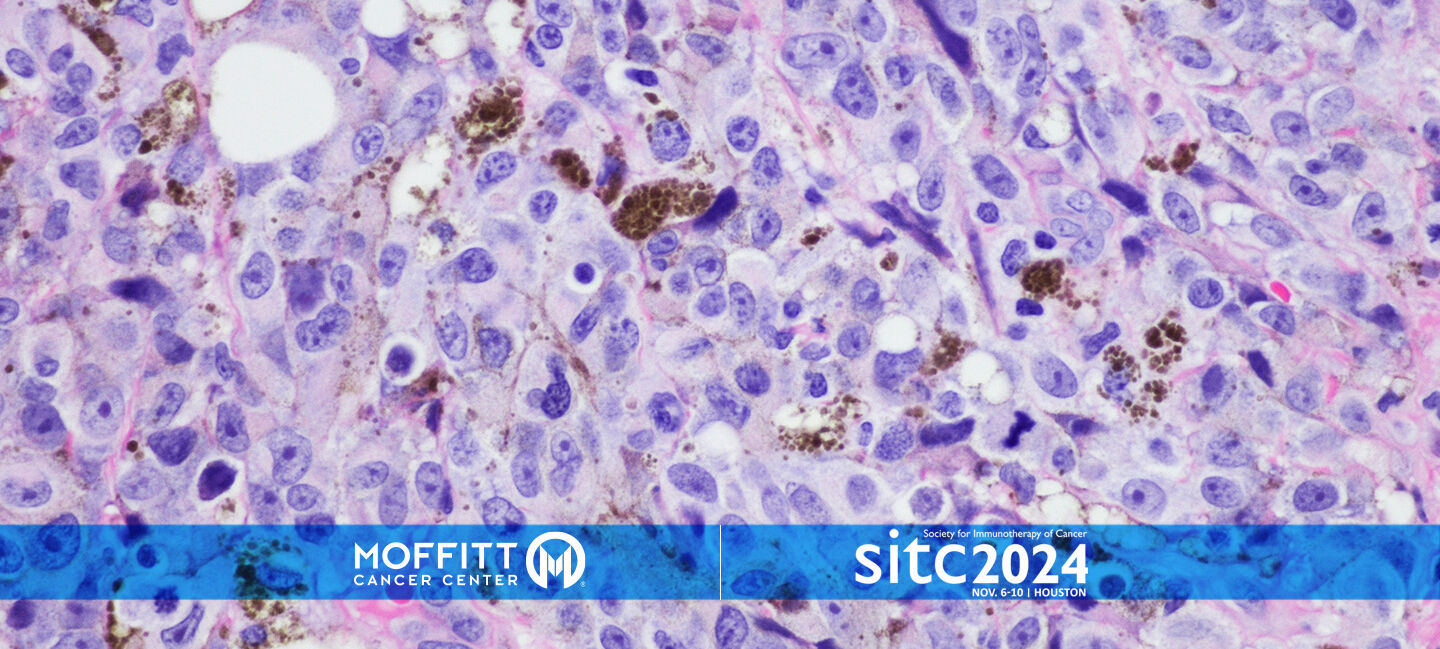

TIL Therapy for Advanced Melanoma Offers Promising Results
Tumor-infiltrating lymphocyte (TIL) therapy is a type of cancer treatment that involves collecting immune cells from a patient’s tumor, multiplying them in a lab and then infusing them back into the patient to help the immune system attack cancer cells.
TIL therapy was approved by the U.S. Food and Drug Administration in February, after more than a decade of investigating the treatment for advanced melanoma.
Moffitt Cancer Center played a pivotal role in the FDA approval of TIL, and a team at the cancer center recently analyzed four early stage clinical trials involving 60 melanoma patients over 10 years. The average age of patients was 49, and 58% were men. Participants received TIL therapy alone or combined with other immunotherapies used for advanced stages of melanoma, such as ipilimumab, nivolumab or vemurafenib. The pooled analysis was recently presented at the Society for Immunotherapy of Cancer annual meeting in Houston.

Lilit Karapetyan, MD
“In this analysis, we don’t only report the data on patients who were actually able to get their TIL cells, but also the ones that are what we call ‘intention to treat analysis,’” said Lilit Karapetyan, MD, an assistant member in the Cutaneous Oncology Department and the presenting author of this analysis. “Not all patients who started the TIL therapy process received treatment. Among the 60 patients evaluated, 10 dropped out. Most commonly, they demonstrated disease progression before proceeding with TIL.”
The study evaluated two key outcomes: progression-free survival — the length of time patients lived without the disease worsening — and overall survival, which determines how long the patients lived overall. On average, those who underwent treatment experienced a progression-free survival of 10 months and an overall survival of 52 months. These results show that TIL therapy can significantly prolong survival for patients with advanced melanoma.
The analysis also showed that 36% of patients experienced a positive response to the therapy. Researchers noted several factors influenced the effectiveness of the treatment. For example, patients who received more TIL cells, especially with a high number of immune cells called CD8+, had better outcomes. However, patients whose cancer had metastasized to the liver tended to have a poorer response to treatment.
“As research continues, our goal is to improve the quality of TIL by modifying TIL expansion rates and enhancing the TIL phenotype, or characteristics, so that more patients benefit from this therapy,” Karapetyan said.
At #SITC24, Lilit Karapetyan, MD (@KarapetLilit) presents promising results for advanced #melanoma with TIL therapy. The study shows 36% of patients experienced a positive response to the therapy.
— Moffitt Cancer Center (@MoffittNews) November 8, 2024
Learn more ➡️ https://t.co/hLxgrYndHJ#MoffittSITC24 @sitcancer pic.twitter.com/6qBdP8CXgG
TIL therapy is a promising treatment for advanced melanoma and offers hope to those with limited options. Karapetyan encourages melanoma patients to get evaluated for TIL therapy, even at early treatment stages.